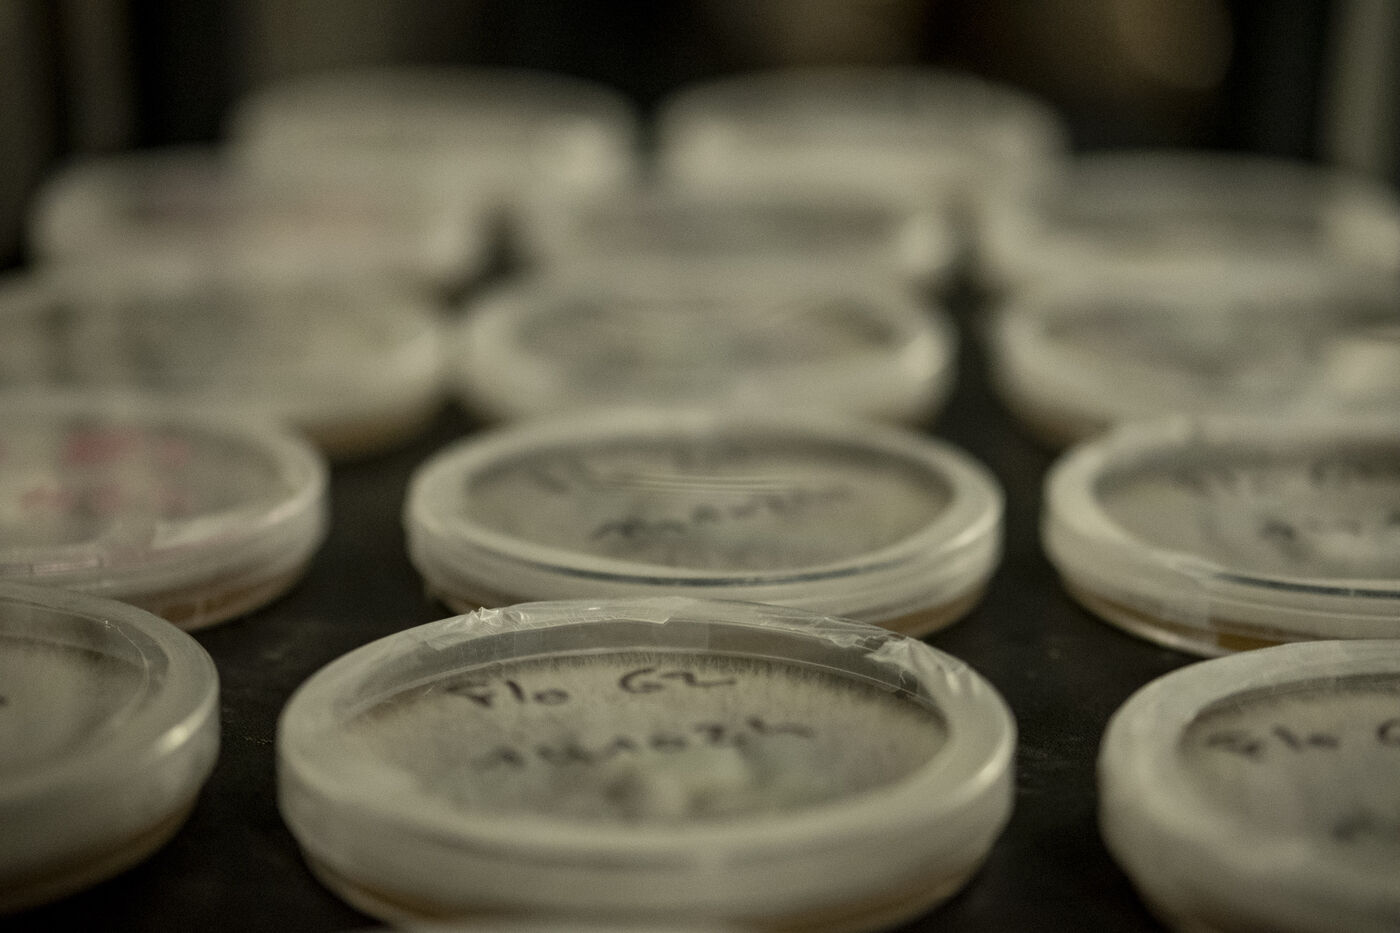

Immersion au coeur d'une champignonnière
« Transformer les déchets en ressources », tel est le principe au fondement de l’économie circulaire. Mais c’est également le défi que s’est lancé Jean-Luc Kantapareddy, myciculteur en Guadeloupe à partir de la bagasse de canne à sucre. Peu après la crise du Covid, il s'engage avec son épouse dans ce projet, en créant au fond de leur jardin, leur « usine à champignons ».
Leur souhait ? Proposer aux consommateurs guadeloupéens des champignons frais, de qualité, produits localement. Offrir de véritables alternatives sur une île qui dépend cruellement des importations, notamment sur le plan alimentaire. Et contribuer ce faisant à alimenter un cercle vertueux : circuit court, repas locavore…
Installée dans deux containers isothermes, la champignonnière produit actuellement deux variétés de pleurotes adaptées au climat tropical : la pleurote des Indes et la pleurote Florida. D’autres espèces en cours d’expérimentation seront cultivées prochainement.
Visite de cette exploitation familiale, située au nord-est de la Grande-Terre et découverte des différentes phases du cycle de culture du champignon, de la production du substrat de culture à la récolte, jusqu’à la valorisation de la matière résiduelle en compost.
Immersion in the heart of a mushroom farm
‘Turning waste into resources’ is the principle behind the circular economy. But this is also the challenge taken up by Jean-Luc Kantapareddy, a myciculturist in Guadeloupe using sugar cane bagasse. Shortly after the Covid crisis, he and his wife embarked on this project, creating their ‘mushroom factory’ at the bottom of their garden.
Their aim? To offer Guadeloupean consumers fresh, high-quality, locally-produced mushrooms. To offer real alternatives on an island that is cruelly dependent on imports, particularly for food. And in so doing, help to fuel a virtuous circle: short circuits, locavore meals...
Housed in two insulated containers, the mushroom farm currently produces two varieties of oyster mushroom adapted to the tropical climate: Indian oyster mushroom and oyster mushroom Florida. Other species are currently being tested and will be cultivated in the near future.
Take a tour of this family-run farm, located in the north-east of Grande-Terre, and discover the different phases in the mushroom growing cycle, from the production of the growing medium to harvesting, right through to the recycling of the residual material as compost.